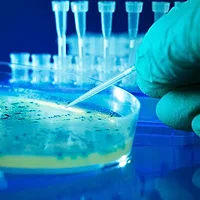

New Inlabtec Serial Diluter UA: A Cost Effective, Greener Upgrade for Serial Dilutions

iNLABTEC AG has introduced the new Serial Diluter UA with an integrated, highly efficient bag mixer that is universally suitable for preparing serial dilutions of all sample types including viscous, high-fat, or sugar-containing samples such as cream, egg yolk, syrup, etc. for microbiological analysis.
The integrated Stomacher-type bag mixer is specifically designed for use with the iNLABTEC Serial Dilution Bags, to prepare sample dilutions for the microbiological testing of food, feed, water, cosmetics, probiotics, etc. The bags are optimized for maximum performance with minimal material usage.
The homogeneity of the dilutions performed with the Serial Diluter UA is excellent and compared to pre-filled disposable containers, the amount of waste produced is at least 10 times less as well as reducing the cost by up to 90 percent.
With the new Serial Diluter UA all common types of pipette tips, filter tips, straws, etc. can be used without exception. The basic operation is identical to the standard method and therefore conforms to ISO methods. The differences for technicians are that pipetting is done into a bag instead of into a test tube followed by ergonomic, automatic mixing instead of manual mixing. In addition, as there is no handling of tubes and caps, and workflow is improved with less risk of repetitive strain injury. Overall, dilutions are more efficient and less prone to errors with no need for changing internal validated lab protocols.
The New Serial Diluter UA will be presented at the 2019 IAFP Annual Meeting, July 21-24 in Louisville, KY, at booth #413 in collaboration with Seward Laboratory Systems, Inc.
Looking for quick answers on food safety topics?
Try Ask FSM, our new smart AI search tool.
Ask FSM →